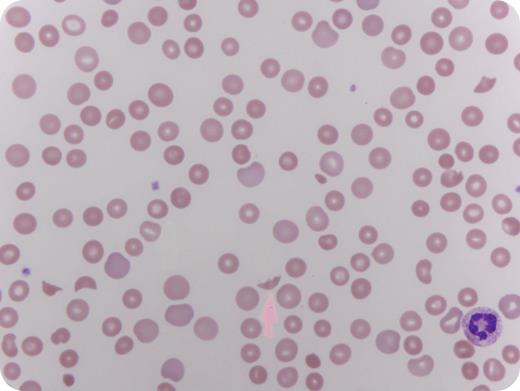
A 23-year-old white woman with a history of intravenous drug abuse presented to the emergency department with decreased level of consciousness, chest discomfort, and shortness of breath. Blood work showed anemia (hemoglobin, 7.6 g/dL), thrombocytopenia (platelet count, 69 000/μL), and evidence of hemolysis as reflected by elevated lactate dehydrogenase, undetectable haptoglobin, and brisk reticulocyte response. Iron indices, B12, and folate were within normal limits. A peripheral smear indicated microangiopathic hemolysis with red blood cell fragmentation (schistocytes and helmet cells, arrow). The patient had been abusing Opana ER 30 mg tablets by crushing and self-injecting up to 8 times daily. She was started on plasma exchange for a thrombotic thrombocytopenic purpura–like syndrome, and her hematological parameters normalized after 1 week of therapy. No evidence of concomitant infection was found. Interestingly the patient maintained normal creatinine and a disintegrin and metalloproteinase with thrombospondin motif 13 (ADAMTS13) activity. / The patient was counseled on the risk of blood-borne infections associated with intravenous drug abuse. This association has recently been reported by clinicians at the Tennessee Department of Health and was published in January 2013 by Marder et al in the Mortality and Morbidity Weekly Report by the Centers for Disease Control. Thus, identifying and screening for intravenous abuse with Opana ER in patients who present with TTP-like syndrome is recommended.

A 23-year-old white woman with a history of intravenous drug abuse presented to the emergency department with decreased level of consciousness, chest discomfort, and shortness of breath. Blood work showed anemia (hemoglobin, 7.6 g/dL), thrombocytopenia (platelet count, 69 000/μL), and evidence of hemolysis as reflected by elevated lactate dehydrogenase, undetectable haptoglobin, and brisk reticulocyte response. Iron indices, B12, and folate were within normal limits. A peripheral smear indicated microangiopathic hemolysis with red blood cell fragmentation (schistocytes and helmet cells, arrow). The patient had been abusing Opana ER 30 mg tablets by crushing and self-injecting up to 8 times daily. She was started on plasma exchange for a thrombotic thrombocytopenic purpura–like syndrome, and her hematological parameters normalized after 1 week of therapy. No evidence of concomitant infection was found. Interestingly the patient maintained normal creatinine and a disintegrin and metalloproteinase with thrombospondin motif 13 (ADAMTS13) activity.
The patient was counseled on the risk of blood-borne infections associated with intravenous drug abuse. This association has recently been reported by clinicians at the Tennessee Department of Health and was published in January 2013 by Marder et al in the Mortality and Morbidity Weekly Report by the Centers for Disease Control. Thus, identifying and screening for intravenous abuse with Opana ER in patients who present with TTP-like syndrome is recommended.
A 23-year-old white woman with a history of intravenous drug abuse presented to the emergency department with decreased level of consciousness, chest discomfort, and shortness of breath. Blood work showed anemia (hemoglobin, 7.6 g/dL), thrombocytopenia (platelet count, 69 000/μL), and evidence of hemolysis as reflected by elevated lactate dehydrogenase, undetectable haptoglobin, and brisk reticulocyte response. Iron indices, B12, and folate were within normal limits. A peripheral smear indicated microangiopathic hemolysis with red blood cell fragmentation (schistocytes and helmet cells, arrow). The patient had been abusing Opana ER 30 mg tablets by crushing and self-injecting up to 8 times daily. She was started on plasma exchange for a thrombotic thrombocytopenic purpura–like syndrome, and her hematological parameters normalized after 1 week of therapy. No evidence of concomitant infection was found. Interestingly the patient maintained normal creatinine and a disintegrin and metalloproteinase with thrombospondin motif 13 (ADAMTS13) activity.
The patient was counseled on the risk of blood-borne infections associated with intravenous drug abuse. This association has recently been reported by clinicians at the Tennessee Department of Health and was published in January 2013 by Marder et al in the Mortality and Morbidity Weekly Report by the Centers for Disease Control. Thus, identifying and screening for intravenous abuse with Opana ER in patients who present with TTP-like syndrome is recommended.
For additional images, visit the ASH IMAGE BANK, a reference and teaching tool that is continually updated with new atlas and case study images. For more information visit http://imagebank.hematology.org.